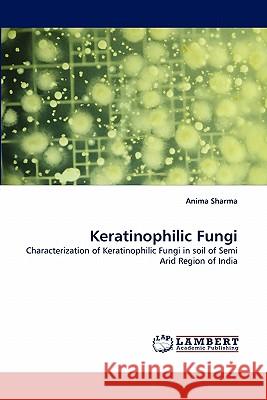
Keratinophilic Fungi Anima Sharma 9783844315752 LAP Lambert Academic Publishing - książka

Keratinophilic Fungi » książka
Keratinophilic Fungi
ISBN-13: 9783844315752 / Angielski / Miękka / 2011 / 112 str.
Soil has long been recognized as a natural habitat for kratinophilic fungi. They are scavengers and serve to break the complex organic compounds including the keratin containing material. Keratinophilic fungi has high industrial and medicinal potential and abundance in the soil, most of these fungi are neither deposited in Indian Culture Collections nor available with the scientists working on them. Therefore, there is an urgent need to isolate and conserve these fungi for exploitation of their biotechnological potential. Non-pathogenic strains of ketatinophilic fungi with high production rate of keratinase can be a very important tool in the eco-friendly bioremediation technologies.
Soil has long been recognized as a natural habitat for kratinophilic fungi. They are scavengers and serve to break the complex organic compounds including the keratin containing material. Keratinophilic fungi has high industrial and medicinal potential and abundance in the soil, most of these fungi are neither deposited in Indian Culture Collections nor available with the scientists working on them. Therefore, there is an urgent need to isolate and conserve these fungi for exploitation of their biotechnological potential. Non-pathogenic strains of ketatinophilic fungi with high production rate of keratinase can be a very important tool in the eco-friendly bioremediation technologies.